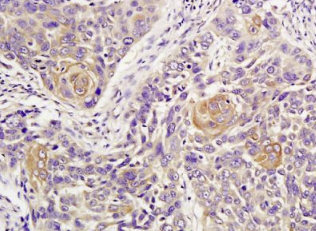

英文名称:Anti-ATM
中文名称:毛细血管扩张性共济失调症突变蛋白抗体
抗体来源:兔
克隆类型:多克隆
交叉反应:人、大鼠、小鼠
产品应用:ELISA=1:500-1000 IHC-P=1:400-800 IHC-F=1:400-800 Flow-Cyt=1μg/Test IF=1:100-500(石蜡切片需做抗原修复)
尚未在其他应用程序中测试。
用户终应确定合适稀释浓度。
分子量:370kDa
细胞定位:细胞核 细胞浆
状态:冻干或液体
浓度:1mg/ml
来源于:KLH conjugated synthetic peptide derived from human ATM:2681-2750/3066
亚型:IgG
纯化方法:affinity purified by Protein A
储存液:0.01M TBS(pH7.4) with 1% BSA, 0.03% Proclin300 and 50% Glycerol.
别 名:ataxia telangiectasia mutated; AT complementation group A; AT complementation group C; AT complementation group D; AT complementation group E; AT mutated; AT protein; AT1; ATA; Ataxia telangiectasia gene mutated in human beings; ATC; ATDC; ATE; ATM; DKFZp781A0353; Human phosphatidylinositol 3 kinase homolog; MGC74674; Serine protein kinase ATM; T cell prolymphocytic leukemia; TEL1; TPLL.
保存条件:在-20°C下保存一年。避免重复冻融循环。冻干抗体在室温下至少稳定一个月,并在-20°C下保持一年以上。当在无菌pH7.4 0.01M PBS或抗体稀释剂中重组时,抗体在2-4°C下至少稳定两周。
产品介绍
ATM是一种参与常染色体隐性疾病共济失调毛细血管扩张症(AT)的370kDa核磷蛋白。atm属于一个新的蛋白质家族,与细胞周期调节、凋亡和对DNA损伤修复的反应(由电离辐射激活atm激酶引起的DNA损伤)有关。C末端区域与磷脂酰肌醇3激酶(PI3激酶)的催化域有广泛的同源性。
功能:
丝氨酸/苏氨酸蛋白激酶,在双链断裂(dsb)、细胞凋亡和基因毒性应激(如电离紫外线A光(uva))时激活检查点信号,从而充当DNA损伤传感器。识别双链断裂(dsbs)组蛋白变体h2ax/h2afx的底物*序列[st]-q.磷酸化“ser-139”,从而调节DNA损伤反应机制。也在B细胞前等位基因排斥中起作用,这是一个导致单个免疫球蛋白重链等位基因表达的过程,以加强B细胞抗原受体(BCR)在单个B淋巴细胞上表达的克隆性和单特异性识别。在一个免疫球蛋白等位基因上的RAG复合物引入DNA后,通过将第二等位基因重新定位到着丝粒周围异染色质来起作用,防止对RAG复合物的可及性和第二等位基因的重组。也参与信号转导和细胞周期控制。可能作为肿瘤抑制剂发挥作用。激活abl1和sapk所必需的。磷酸化p53/tp53、fancd2、nfkbia、brca1、ctip、nibrin(nbn)、terf1、rad9和dclre1c。可能在囊泡和/或蛋白质转运中起作用。可能在T细胞发育、性腺和神经功能中起作用。在复制依赖组蛋白的mRNA降解中起作用。结合DNA结束。
亚细胞位置:
细胞核。胞质囊泡。主要是核。也发现在与β-适应性蛋白相关的内囊泡中。
组织特异性:
见于胰腺、肾脏、骨骼肌、肝脏、肺、胎盘、大脑、心脏、脾脏、胸腺、睾丸、卵巢、小肠、结肠和白细胞。
翻译后修改:
由nuak1/ark5磷酸化。SER-367、SER-1893、SER-1981上的自磷酸化与DNA损伤介导的激酶激活相关。
在DNA损伤时,乙酰化是激活激酶活性、二聚体单体转化以及随后在SER-1981上自磷酸化所必需的。kat5/tip60体外乙酰化。
疾病:
ATM的缺陷是引起共济失调毛细血管扩张症(AT)的原因[MIM:208900];又称Louis Bar综合征,包括4个互补组:A、C、D和E。这种罕见的隐性疾病的特征是进行性小脑性共济失调、结膜和眼球血管扩张、免疫缺陷、生长迟缓和性不成熟。AT患者易患癌症,约30%的患者发展为肿瘤,特别是淋巴瘤和白血病。受影响个体的细胞对电离辐射的损伤高度敏感,对辐照后DNA合成的抑制具有抵抗力。
注=ATM缺陷导致T细胞急性淋巴细胞白血病(TALL)和T淋巴细胞白血病(TPLL)。TPLL的特点是白血球计数高,主要有淋巴母细胞、明显的脾肿大、淋巴结肿大、皮肤损伤和浆液性渗出。临床进程是高度侵略性,化疗反应差,生存时间短。TPLL既发生在成人身上,也发生在年轻人身上。
注=ATM缺陷导致B细胞非霍奇金淋巴瘤(BNHL),包括套细胞淋巴瘤(MCL)。
注=ATM的缺陷导致B细胞慢性淋巴细胞白血病(bcll)。bcll是老年人较常见的白血病。以成熟的CD5+B淋巴细胞聚集、淋巴结病、免疫缺陷和骨髓衰竭为特征。
相似性:
属于PI3/PI4激酶家族。ATM亚族。
包含1个FAT域。
包含1个FATC域。
包含1个PI3K/PI4K域。
重要注意事项:
通道蛋白(Channel Protein)
钠钾ATP酶是位于细胞膜上的一种糖蛋白,与ATP 的分解和细胞内外钠、钾离子的转运密切相关,哺乳动物各种组织细胞的钠钾ATP 酶的免疫学特性基本相同。
本产品仅用于研究用途,不用于人类、治疗或诊断应用。
组织/细胞:人肺癌;4%多聚甲醛固定石蜡包埋;
抗原提取:柠檬酸缓冲液(0.01M,pH 6),15min煮沸,用3%过氧化氢阻断内源性过氧化物酶30min;37℃下阻断缓冲液(正常山羊血清)20 min;
孵育:抗ATM多克隆抗体,未结合(BS-1370R)1:300,4°C下过夜,然后与二级抗体结合,DAB染色。
公司优势:
1)质量:我司提供的的试剂为世界
2)价格:价格实惠,量大从优。
4)服务:提供完整的售前、售后和售中服务。售后到底
如需订购毛细血管扩张性共济失调症突变蛋白抗体,请联系我们。
| Anti-HGV(Hepatitis G vivus) 庚型肝炎病毒抗体 |
| Anti-HHV4/EBV(Human herpesvirus 4 type 2/epstein-barr virus ) 人类疱疹病毒4抗体 |
| Anti-HHV8/ORF K2/vIL-6(Human herpesvirus 8) 人类疱疹病毒8抗体 |
| Anti-HHV8/ORF50(Human herpesvirus 8 type P) 人类疱疹病毒8抗体 |
| Anti-HHV8/ORF50(Human herpesvirus 8 type P) 人类疱疹病毒8抗体 |
| Anti-HHV8/ORF50(Human herpesvirus 8 type P) 人类疱疹病毒8抗体 |